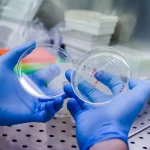
ARI-0001 muestra altas tasas de respuesta en pacientes adultos con leucemia linfoblástica

La Agencia Española del Medicamento y Productos Sanitarios (Aemps) ha aprobado el ensayo clínico CARxALL liderado por la empresa OneChain Immunotherapeutics (OCI). Se trata de un ensayo único en el mundo con tecnología CAR-T para pacientes con un subtipo de leucemia de células T.
El ensayo CARxALL permitirá evaluar por primera vez la terapia CD1a CAR-T (OC-1), dirigida de manera específica a un subtipo de leucemia de tipo T: la leucemia linfoblástica aguda de células T corticales (coT-ALL), que supone el 30%-40% de las T-ALL y que tiene mal pronóstico en aquellos pacientes que no responden a los tratamientos actuales.
La producción en condiciones clínicas de la terapia CD1a CAR-T para el ensayo ha sido liderada por Maria Castellà, facultativa del Servicio de Inmunología del Centro de Diagnóstico Biomédico del Hospital Clínic de Barcelona dirigido por Manel Juan.
Este ensayo se llevará a cabo en Barcelona, en el Hospital Clínic y el Hospital Sant Joan de Déu bajo la dirección de Núria Martínez y Susana Rives, investigadoras principales de este estudio.
Está previsto incluir a pacientes tanto pediátricos como adultos que no disponen de ninguna alternativa terapéutica. Aunque el tratamiento se hará en Barcelona, al ensayo se podrán incorporar pacientes no solo de España sino de toda Europa.
El equipo liderado por Pablo Menéndez, fundador de OCI y director del grupo de Biología de Células Madre, Leucemia del Desarrollo e Inmunoterapia del Instituto de Investigación contra la Leucemia Josep Carreras, ha sido el primero del mundo en desarrollar y validar un CAR-T específico para CD1a para coT-ALL. El trabajo, liderado por el Dr. Diego Sánchez y publicado en las revistas Blood y Journal ImmunoTher Cancer, se ha realizado con modelos animales utilizando células derivadas de pacientes con coT-ALL. Los resultados preliminares muestran que estos CAR-T persisten in vivo a largo plazo y retienen la actividad antileucémica.
El ensayo clínico CARxALL es un paso adelante para desarrollar inmunoterapia celular adoptiva, como los CAR-T, un tratamiento que consiste en extraer las células T del paciente (las encargadas de la defensa de nuestro organismo), modificarlas en laboratorio y volvérselas a infundir. La modificación permite que estas células ataquen los receptores que se encuentran en la membrana de las células tumorales y las eliminen. Con esta técnica, son las células modificadas del propio paciente las que atacan las células cancerosas de forma dirigida, sin dañar las células sanas.
OCI ha conseguido este hito tan relevante tras haber sido constituida en 2020 con una ronda de capital semilla de 3 millones de Euros por parte de Invivo Ventures, CDTI-Innvierte y la Fundación Josep Carreras y tras conseguir financiación por parte de la Agencia Estatal de Innovación. Este es un caso de éxito de transferencia tecnológica y de colaboración público-privada, que supone una recuperación de la inversión pública en investigación.
Según Menéndez, “es muy complicado, en el ámbito académico, desarrollar estas estrategias y gestionar todos los mecanismos regulatorios asociados al desarrollo de un producto. Por ello, OCI nos permite llevar a cabo todos los pasos necesarios con el objetivo de que nuestro conocimiento llegue al paciente”.
Antoni Garcia Prat, gerente de la Fundación Josep Carreras, afirma que “la Fundación decidió acompañar la inversión inicial de Invivo Ventures y CDTI como señal de apoyo a la investigación transferida y al equipo investigador, teniendo muy en cuenta que los proyectos se dirigen a tumores hematológicos minoritarios, pediátricos o con pocas alternativas terapéuticas. En caso de generarse retorno económico para la Fundación, este revertirá íntegramente en la lucha contra la leucemia, siempre en beneficio de los pacientes”.
El profesor Evarist Feliu, presidente de la Comisión Delegada del Instituto de Investigación contra la Leucemia Josep Carreras, comenta: «la inmunoterapia constituye en la actualidad un gran escenario para el tratamiento del cáncer. Su máximo interés clínico se centra actualmente en los inhibidores de los checkpoint del sistema inmune y las estrategias de terapia adoptiva con células T, con más de 700 ensayos clínicos en todo el mundo para el tratamiento de las hemopatías malignas y, en menor medida, de los tumores sólidos».
Lluís Pareras y Albert Ferrer, socios fundadores de Invivo Ventures, han señalado que «OneChain está desarrollando varios programas en el ámbito de los CAR-T fruto de la transferencia de tecnología. Con su primer programa, OCI ha demostrado la capacidad de llevar un producto de resultados académicos a ensayo clínico en tan solo dos años. Además, cuenta en su pipeline con una nueva plataforma alogénica, un programa contra tumores hematológicos y otro contra tumores sólidos».

César Hernández, director general de Cartera y Farmacia del Ministerio de Sanidad:
Kilian Sánchez, secretario de Sanidad del PSOE y portavoz de la Comisión de Sanidad del Senado.:
Rocío Hernández, consejera de Salud de Andalucía:
Nicolás González Casares, eurodiputado de Socialistas & Demócratas (S&D - PSOE):
Juan José Pedreño, consejero de Salud de Murcia: